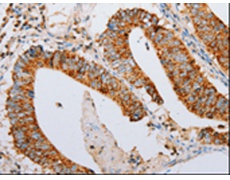
一抗

中文名稱:兔抗ARF6多克隆抗體
|
Background: |
This gene encodes a member of the human ARF gene family, which is part of the RAS superfamily. The ARF genes encode small guanine nucleotide-binding proteins that stimulate the ADP-ribosyltransferase activity of cholera toxin and play a role in vesicular trafficking and as activators of phospholipase D. The product of this gene is localized to the plasma membrane, and regulates vesicular trafficking, remodelling of membrane lipids, and signaling pathways that lead to actin remodeling. A pseudogene of this gene is located on chromosome 7. |
|
Applications: |
ELISA, WB, IHC |
|
Name of antibody: |
ARF6 |
|
Immunogen: |
Synthetic peptide of human ARF6 |
|
Full name: |
ADP-ribosylation factor 6 |
|
SwissProt: |
P62330 |
|
ELISA Recommended dilution: |
2000-10000 |
|
IHC positive control: |
Human colon cancer |
|
IHC Recommend dilution: |
10-50 |
|
WB Predicted band size: |
20 kDa |
|
WB Positive control: |
HepG2 and 231 cells |
|
WB Recommended dilution: |
500-2000 |


 購(gòu)物車
購(gòu)物車 幫助
幫助
 021-54845833/15800441009
021-54845833/15800441009